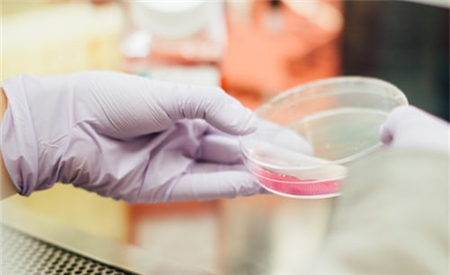

食品检测已成为监管食品质量安全的常态化管理方式,并随着国家对食品质量安全的高度重视以及食品安全知识的普及,食品检测逐渐被大众所了解认识。食品检测最开始是由国家相关部门主持实施,但我国人口基数大、市场结构复杂多样,单由相关部门主持实施较为困难且存在公信力不足问题,于是在市场的鼓励、扶持下出现了第三方食品检测机构,协助食品检测的进行。

那么作为消费者应该如何去挑选合适的第三方检验机构呢?
首先,食品检测第三方机构要做食品检测,必需要取得食品资质认定。只有取得资质认定的机构才可以出具检测报告。食品检验机构应当按照国家有关认证认可的规定依法取得资质认定后,方可从事食品检验活动。未依法取得资质认定的食品检验机构,不得向社会出具具有证明作用的检验数据和结果。食品检验机构应当符合国务院卫生行政部门规定的资质认定条件。
其次,要判断该机构的规模:一般而言规模较大的实验室在人员配备方面会更加齐全和一些;规模较小的实验室,在人员配置上会相对简单一些;大型实验室的人员配备会更全面一些,而小型实验室的人员配备则会更加精简一些。
在国内来说,食品检测机构还是比较多的,安徽国科检测科技有限公司(以下简称“国科检测”)是一家在全国范围内为市场监管部门及企业提供一站式综合解决方案的中国第三方检测与认证行业排头兵,不断探索和研究新一代信息技术在食品安全领域的应用,为创新食品安全监管提供有效技术和服务保障。